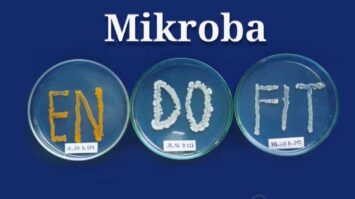
pengertian-mikroba-endofit-9320674-2089342-jpg

Rumah Adat, Pakaian, Tarian dan Agama
Untuk pembahasan kali ini kami akan mengulas mengenai suku ambon yang dimana dalam hal ini meliputi pengertian, rumah adat, pakaian, tarian, makanan, agama, kepercayaan, nah agar lebih memahami dan dimengerti…

Pengertian, Macam, Pola, Unsur dan Tanda
Pengertian Birama Birama adalah suatu tanda untuk menunjukkan jumlah ketukan dalam satu ruas birama. Satu ruas birama ditunjukkan oleh batas-batas garis vertikal yang disebut garis birama. Hal ini terlihat dalam…

Anatomi Bagian Bagian Telinga Terlengkap
Pengertian Telinga Anatomi Bagian Bagian Telinga Terlengkap – Telinga ialah saluran yang terbuka pada bagian luar dan juga bersatu dengan tulang tengkorak. Telinga pada manusia tersusun dari tiga bagian utama, yakni bagian: Anatomi Telinga telinga…

Apa itu Surat Edaran – DUNIA PENDIDIKAN
Pengertian Surat Edaran Surat Edaran merupakan surat tertulis yang berisi pemberitahuan resmi yang ditujukan pada pihak-pihak tertentu di dalam sebuah instansi, lembaga, atau organisasi. Jadi, definisi surat…

Kalimat Komunikatif – Contoh, Syarat, Kaidah, Unsur, Santun
Kalimat Komunikatif – Contoh, Syarat, Kaidah, Unsur, Penempatan, Santun : Merupakan satuan bahasa berupa kata atau rangkaian kata yang dapat berdiri sendiri dan menyatakan makna yang lengkap. Pengertian Kalimat Komunikatif…
Pengertian, Jenis, Manfaat, dan Sifat
Mikroba Endofit : Pengertian, Jenis, Manfaat, & Sifat adalah mikroba yang hidup di dalam jaringan tanaman pada periode tertentu dan mampu hidup dengan membentuk koloni dalam jaringan tanaman tanpa membahayakan…

Pengertian, Faktor, Syarat, Jenis, Bentuk & Dampak
Hubungan Sosial : Pengertian, Faktor, Syarat, Tujuan, Jenis, Bentuk dan Dampak Adalah hubungan yang dinamis yang menyangkut hubungan antar individu, antar kelompok, antar orang dengan kelompok Baca Juga Artikel Yang…

Pengertian, Prinsip Archimedes dan Rumus
Gaya Apung : Pengertian, Prinsip Archimedes dan Rumus Adalah kemampuan suatu benda mengapung dalam cairan ataupun fluida. Hubungan berat benda dengan berat air yang dipindahkan ialah apa yang menentukan jika…

Pengertian Impedansi, Rumus, Speaker, Hambatan & Perbedaan
Pengertian Impedansi, Rumus, Speaker, Hambatan dan Perbedaan : adalah hasil gabungan dari nilai resistor dan reaktansi(hambatan dan Y) dalam rangkaian AC (alternating current) Nilai reaktansi berasal dari nilai hambatan yang…

Pengertian, Struktur, Tujuan, Unsur, Ciri
Pengertian Proposal Yang dimaksud dengan proposal adalah tulisan yang dibuat oleh penulis dengan maksud untuk menjelaskan rencana dan tujuan suatu kegiatan kepada para pembaca, sehingga mereka mendapatkan pemahaman tentang tujuan…
